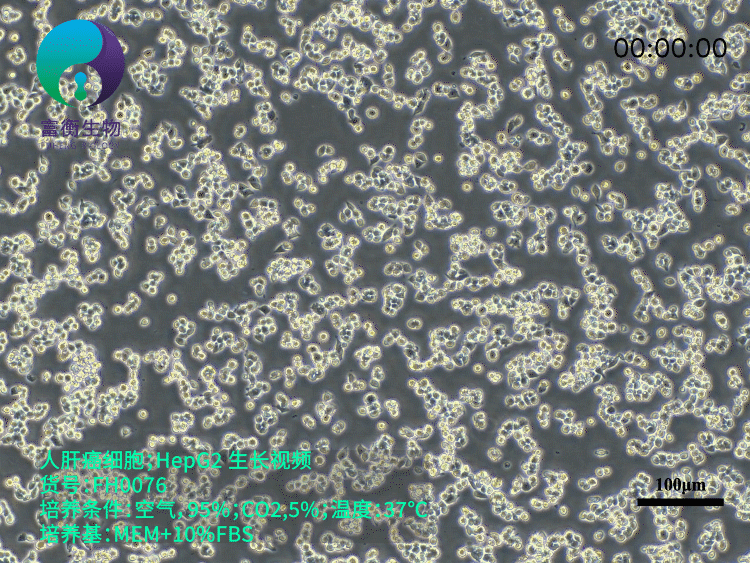
技术资料图片2

上海富衡生物科技有限公司品牌商
5 年
手机商铺
商家活跃:
产品热度:
- NaN
- 0.20000000000000018
- 0.20000000000000018
- 2.2
- 2.2
品牌商
上海富衡生物科技有限公司
入驻年限:5 年
- 联系人:
刘胜富
- 所在地区:
上海 闵行区
- 业务范围:
抗体、ELISA 试剂盒、细胞库 / 细胞培养、论文服务、试剂、实验室仪器 / 设备、技术服务、耗材
- 经营模式:
代理商 经销商 生产厂商 科研机构
推荐产品
技术资料/正文
上海富衡 | 人肝癌细胞 HepG2
447 人阅读发布时间:2025-04-28 09:11
一、HepG2细胞的生物学特性
HepG2细胞是肝癌研究的核心工具细胞系,于1975年从一名15岁白人男性肝母细胞瘤(原误诊为肝细胞癌)患者的肿瘤组织中分离建立其生物学特性包括:
- 形态与标志物:呈上皮样贴壁生长,表达甲胎蛋白(AFP)、白蛋白、α-1抗胰蛋白酶等肝特异性蛋白,并保留胰岛素受体及IGF-II受体活性。
- 代谢功能:具有3-羟基-3-甲酰辅酶A还原酶和肝甘油三酯脂肪酶活性,但细胞色素P450(CYP)等药物代谢酶表达显著低于原代肝细胞。
- 基因组特征:不含乙型肝炎病毒(HBV)基因组,但携带TP53突变等遗传异常,与肝癌临床特征高度吻合。

二、HepG2的标准化培养体系
1. 培养基与传代优化
- 基础配方:推荐使用MEM或DMEM培养基(含10%胎牛血清+1% NEAA),维持pH 7.2-7.4以保障细胞贴壁。
- 传代管理:消化时间控制在1-3分钟(0.25%胰酶),传代比例1:2~1:4,避免过度吹打导致细胞损伤。
- 首次传代建议保留原代培养基以稳定细胞状态。
2. 常见问题与对策
- 空泡现象:约30%的HepG2细胞胞质内存在空泡,为正常特性,不影响增殖与功能。
- 贴壁困难:血清质量及pH波动是关键因素,可临时提升血清浓度至15%-20%促进贴壁。
- 增殖缓慢:接种密度需>5×10⁴ cells/cm²,倍增时间约48-72小时,低于此阈值需检查支原体污染或培养基成分。
三、HepG2在肝癌研究中的多维应用
1. 药物开发与毒性评估
- 代谢研究:HepG2常用于药物肝毒性测试,但其CYP3A4表达仅为原代肝细胞的1/100,需结合CRISPR编辑技术增强代谢酶活性。
- 抗肿瘤机制:如利拉鲁肽通过激活JNK通路诱导HepG2凋亡,IC50约100 nM。
2. 肿瘤生物学机制解析
- 信号通路调控:靶向PI3K/AKT/mTOR通路可抑制细胞增殖,敲除PRDX6基因可触发线粒体功能障碍与G2/M期阻滞。
- 肿瘤微环境:HepG2来源的外泌体杨氏模量(159.6±51.3 MPa)显著高于非转移性细胞,提示其力学特性与转移潜能相关。
3. 基因编辑与疾病模型
- CRISPR技术突破:通过优化sgRNA设计与转染条件,HepG2基因敲除效率可达80%以上(如Vang11、NR1H4等基因)。
- 3D类器官与CDX模型:构建三维球形培养体系可提升代谢活性,裸鼠皮下移植瘤成瘤率达100%,适用于药物体内外一致性验证。
四、HepG2的局限性及前沿突破
1. 核心挑战
- 代谢功能不足:转运蛋白(如BSEP)表达量仅为原代肝细胞的1/100,限制其在药物代谢预测中的准确性。
- 模型异质性:长期传代导致蛋白表达批次差异,需结合STR鉴定与代谢组学监控细胞稳定性。
2. 技术创新方向
- 多组学整合:联合单细胞转录组与空间代谢组解析肿瘤异质性亚群。
- 人源化模型:将HepG2与免疫细胞共培养构建免疫治疗评价平台。
HepG2细胞作为肝癌研究的“活体数据库”,在基础机制解析与临床前评价中持续发挥不可替代的作用。随着基因编辑技术与类器官模型的进步,其在转化医学中的应用边界正不断拓展,为肝癌精准治疗提供全新突破口。




